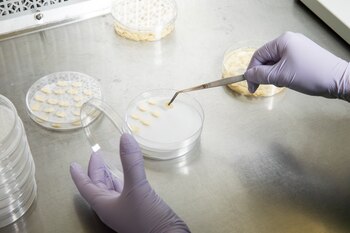
Un investigador trabaja con muestras

Roseville (Minnesota) – En un reluciente laboratorio escondido entre un hotel Hampton Inn y un restaurante Denny's, el centro de investigación de la firma biotecnológica Calyxt trabaja en los controles de un nuevo robot.
La máquina, formada con una especie de pinzas, deja caer fragmentos de ADN en tubos con pipetas, y es capaz de transformar la comida y la agricultura.
Gracias a una tecnología de vanguardia llamada "modificación de genes", los científicos ahora pueden activar y desactivar genes de plantas de forma tan sencilla como los científicos de Calyxt activan un interruptor para iluminar las hileras de plantas de soja que crecen en su laboratorio.
La soja "más saludable" de Calyxt, el primer alimento de la industria verdaderamente modificado, podría abrirse camino y llegar a productos como las papas fritas, los aderezos para ensaladas y los productos horneados.
A diferencia de los métodos de modificación genética más antiguos, las nuevas técnicas son precisas, rápidas y económicas, y las compañías esperan que eviten la reputación negativa y los obstáculos regulatorios que obstaculizaron la primera generación de alimentos genéticamente modificados.
Pero la velocidad del cambio ha sorprendido a los grupos de consumidores y ambientalistas, que dicen que la nueva tecnología no ha sido adecuadamente investigada, y han pedido a los reguladores que agreguen más revisiones de seguridad.

"Esto es algo difícil", señaló Federico Tripodi, director ejecutivo de Calyxt. "Los consumidores aceptan que la tecnología es buena en muchos aspectos de sus vidas, pero la tecnología y la comida han sido algo aterrador. Necesitamos descubrir cómo participar en esa conversación".
La soja de Calyxt es la primera de 23 cultivos modificados genéticamente que el Departamento de Agricultura ha reconocido hasta la fecha.
Los científicos de Calyxt, una subsidiaria de la firma farmacéutica francesa Cellectis, desarrollaron su soja desactivando los genes responsables de las grasas transgénicas en el aceite de soya. En comparación con la versión convencional, dicen fuentes de Calyxt, el aceite elaborado con esta soja contiene muchas más grasas "saludables" y muchas menos grasas que elevan el colesterol malo.
A Tripodi le gusta decir que el producto es similar al aceite de oliva pero sin el sabor picante que lo haría desagradable en Oreos o barritas de granola. Ha ganado elogios del Centro para la Ciencia en el Interés Público, un grupo de consumidores que dice que la salud pública se beneficiará de los ingredientes con menos grasas transgénicas y saturadas, independientemente de cómo se hayan desarrollado.
Dan Voytas, director científico de Calyxt y profesor de ciencias biológicas en la Universidad de Minnesota, señaló que con el advenimiento de la modificación de genes, el ritmo de esas mejoras en los cultivos se está acelerando.

"Nunca anticipé la velocidad a la que se desarrollaba el campo", comentó Voytas recorriendo los húmedos invernaderos donde Calyxt está cultivando junglas frondosas de soja, trigo y canola experimentales.
– – – – – – – – – – –
Los agricultores han tratado de mejorar los cultivos desde sus comienzos. Durante siglos, los agricultores han criado sus plantas más sanas y de mayor rendimiento para producir mejores alimentos. En la década de los ochenta, los científicos también comenzaron a cortar y pegar ADN entre especies en lo que se conoce como ingeniería genética.
Eso provocó una reacción violenta entre los consumidores estadounidenses, de los cuales 4 de cada 10 creen que los alimentos genéticamente modificados son perjudiciales para su salud, según un informe del Centro de Investigación Pew de 2016. La preocupación pública por los organismos genéticamente modificados, o transgénicos, ha impulsado el crecimiento de un mercado multimillonario de alimentos no modificados genéticamente y ha restringido su cultivo en Europa.
Pero los científicos esperan que el público sea menos hostil a CRISPR y TALEN, las herramientas de modificación de genes más populares, por su potencial para mejorar el sabor y el valor nutricional.

Ambos funcionan como diminutas tijeras genéticas, cortando el ADN de una planta en puntos específicos precodificados.
Los investigadores ahora están trabajando para agregar un nuevo código genético en el ADN y no simplemente eliminar lo que ya está allí. También están desarrollando métodos para editar múltiples genes en una sola planta, un objetivo que algunos científicos dicen que pueden lograr en unos pocos años. Una start-up, Inari Agriculture, está apostando por que algún día pueda personalizar las semillas de acuerdo a las condiciones de la granja en la que crecen.
"Creo que, a pesar de toda la exageración sobre la modificación de genes, todos menos algunos escritores de ciencia ficción han subestimado la magnitud de la revolución que están introduciendo", comentó Val Giddings, miembro de la Fundación de Tecnología e Innovación de la Información, un think tank de Washington. "Transformarán drásticamente todos los aspectos de la relación entre los seres humanos y nuestro medio ambientes de manera abrumadoramente positiva".
Los científicos en los laboratorios universitarios y en compañías como Calyxt ya están diseñando plantas que son más nutritivas, convenientes y sostenibles. El bajo costo de la modificación genética ha facultado a los más pequeños con la capacidad de competir en un campo que durante mucho tiempo ha estado dominado por grandes empresas de agronegocios.
Investigadores del Instituto de Agricultura Sostenible de Córdoba (España) han presentado una cepa de trigo con bajo contenido de gluten dirigida al floreciente mercado libre de gluten. La Universidad Estatal de Pensilvania ha desarrollado hongos que no se doran, y el Laboratorio Cold Spring Harbor ha creado tomates adecuados para temporadas de cultivo más cortas.
Mientras tanto, las universidades de todo el país están trabajando en plantas que resistirán las sequías, las enfermedades y los estragos del cambio climático. Dicen los expertos que tales mejoras, que ya se están experimentando en naranjas, uvas y cacao, podrían proteger estas plantas en el futuro mientras se reduce el uso de agua y químicos.

"Tenemos algunos problemas en la agricultura", remarcó Bernice Slutsky, vicepresidenta de política nacional e internacional en la Asociación Americana de Comercio de Semillas. "Ya sea por la sequía, la presión de las enfermedades o el cambio climático, esta es una herramienta que ayuda a abordarlos de manera eficiente".
– – – – – –
Pero incluso cuando se acelera la edición de genes, algunos grupos de consumidores y ambientalistas han comenzado a temer que el campo haya superado a los reguladores. Defensores y críticos por igual coinciden en afirmar que el marco legal de 30 años para la investigación de cultivos genéticamente modificados no ha seguido el ritmo de las innovaciones como CRISPR y TALEN.
Bajo las reglas actuales, el Departamento de Agricultura no requiere pruebas de campo o evaluaciones ambientales para muchos de estos cultivos, como lo hace para la mayoría de los organismos genéticamente modificados convencionales. Esto se debe a que la mayoría de los cultivos modificados genéticamente hasta la fecha, como la soja de Calyxt, no contienen material genético extraño y no se hicieron utilizando las bacterias o los virus que los científicos utilizaron en la primera generación de OGM (Organismo Genéticamente Modificado). La agencia ha dicho que su autoridad se extiende solo a esos métodos, ya que se encarga de proteger a las plantas contra infecciones y plagas. A finales de julio, el máximo tribunal de Europa llegó a la conclusión opuesta al dictaminar que los cultivos modificados genéticamente deberían cumplir con las mismas estrictas regulaciones que los organismos genéticamente modificados.
Mientras tanto, la Administración de Alimentos y Medicamentos (FDA por sus siglas en inglés) supervisa la seguridad alimentaria y la nutrición de los alimentos modificados genéticamente, pero solo si el fabricante solicita una consulta. Calyxt no hizo esa solicitud, según la FDA. La agencia está evaluando si los alimentos modificados genéticamente conllevan riesgos de seguridad adicionales.

Jennifer Kuzma, profesora de ingeniería genética en la Universidad Estatal de Carolina del Norte, tales cambios son necesarios para asegurar a los consumidores que los alimentos modificados genéticamente son seguros.
Jeff Wolt, profesor de agronomía y toxicología recientemente retirado en la Universidad Estatal de Iowa, subrayó que estas fallas ocurren tanto en el laboratorio como en la naturaleza, pero rara vez escapan a la atención de los criadores. Sin embargo, si lo hicieran, los efectos podrían ser dramáticos: evitar el crecimiento, introducir alérgenos y toxinas o exponer la planta a la enfermedad. A finales de la década de los sesenta, los investigadores de la planta aprendieron esto de la manera más difícil cuando desarrollaron una patata frita mejor que también infligía náuseas severas a cualquiera que la comiera.
"Necesitamos un proceso regulatorio obligatorio: no solo por razones científicos, sino también por la confianza del consumidor y del público", manifestó Kuzma. "Creo que la gran mayoría de los alimentos modificados genéticamente van a ser tan seguros como los que han sido cultivados de forma tradicional", agregó.

Los grupos de consumidores también han elevado las alarmas sobre cómo se etiquetarán los alimentos modificados genéticamente. Si bien el Congreso aprobó en 2016 una ley que exige que los fabricantes de alimentos revelen ingredientes genéticamente modificados, esas reglas probablemente no se apliquen a los alimentos elaborados con técnicas más recientes de edición genética, según los expertos que lo revisaron. Calyxt ha comercializado su aceite de soja a los fabricantes de alimentos como "no OGM" citando el hecho de que no contiene material genético extraño.
Michael Hansen, científico de Consumers Union, subrayó que es improbable que los consumidores acepten esta distinción.
Hansen argumenta que los OGM desarrollaron una reputación negativa en parte porque las empresas de biotecnología fracasaron en el alcance público en los años ochenta y noventa. Si las empresas repiten ese error, los consumidores rechazarán una tecnología prometedora.
"No entiendo por qué las empresas no quieren etiquetar. No etiquetar da la impresión de que tienen algo que ocultar, y la aceptación del consumidor dependerá de eso".
Pero las semillas del cambio ya están, literalmente, en el suelo. A una hora del sur de las oficinas de Calyxt, los granos de soja modificados genéticamente de la compañía cubren una larga colina inclinada en la granja de Bob Braun, de 62 años.
Braun es uno de los 75 agricultores que cultivan frijoles Calyxt esta temporada en sus 6.800 hectáreas de tierras de cultivo.
El hombre predice que, dentro de unos años, los consumidores tampoco estarán preocupados por la diferencia entre los alimentos modificados genéticamente y los convencionales. En ese sentido, apostilla que es la última de varias revoluciones en la agricultura moderna.
"Creo que puedes regresar a cualquier momento en la historia de la humanidad y encontrar personas que tuvieran miedo al cambio. Cuando era niño, solía escuchar a los veteranos quejándose de los tractores", relataba.
Últimas Noticias
Resultados del Sudamericano de Clubes de Vóley 2026: así van los partidos de Alianza Lima, San Martín y Regatas Lima
Las ‘íntimas’ aseguraron su pase a las semifinales tras derrotar a las ‘santas’. Las de Santa Anita y las chorrillanas se juegan su chance en la fecha 3 de competición. Revisa los marcadores de cada encuentro del campeonato

Video registró a therians en estación de TransMilenio en Bogotá ante la mirada atónita de otros ciudadanos: las imágenes son virales
El contenido audiovisual da cuenta de varios integrantes del grupo en la estación Temporal Calle 34 en Bogotá. Algunos de ellos llevaban correas en el cuello y avanzaban sujetados por otras personas

El aceite de oliva extra virgen ayuda a preservar la memoria, reveló un estudio
Investigadores de la Universitat Rovira i Virgili, en España, identificaron el vínculo entre su consumo regular y una mejor función cerebral, mediado por la diversidad de bacterias beneficiosas en el intestino

Omar Harfuch confirma investigación de la FGR por resort ligado al CJNG
Estos casos se dieron principalmente en las regiones de Jalisco y Nayarit

Feria de perritos en adopción 2026: fechas y requisitos para encontrar a tu nuevo amigo en CDMX
Te decimos todos los detalles por si estás buscando un animal de compañía


